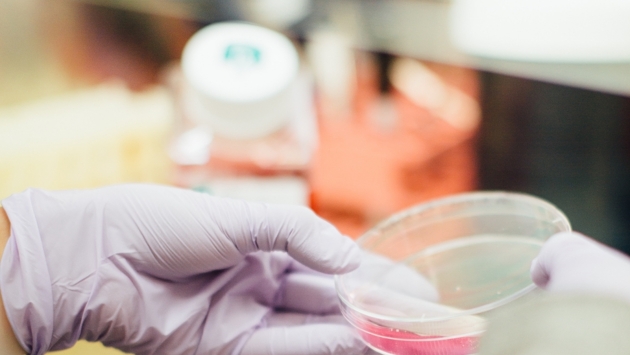

Как связаны ЭКО и онкологические заболевания, объяснила акушер-гинеколог
Проблеме бесплодия ученые уделяют много внимания. Пациентам предлагают разные методы, вспомогательные репродуктивные технологии. Но вокруг темы ЭКО всегда много «страхов».
И главный из них – риск появления рака после проведения экстракорпорального оплодотворения. Акушер-гинеколог ФНКЦ ФМБА России Ирина Вячеславовна Закарян напоминает: еще не удалось обнаружить прямых доказательств, что ЭКО провоцирует образование рака.
– Уже прошло более 40 лет с момента, когда родился первый человек «из пробирки», – отмечает Ирина Вячеславовна Закарян. – Все это время ученые всего мира ведут наблюдения и исследования. Были статьи, в которых прослеживалась связь между раком и ЭКО, но вскоре печатались опровержения. В то же время рак выявляется и у женщин, которые забеременели самостоятельно.
Изучение возможной связи ЭКО и онкологии продолжается. Но пока у ученых нет ответа на самый важный вопрос – откуда берется рак.
Акушер-гинеколог подчеркнула, что при планировании беременности – не важно, естественным путем или с помощью методов ВРТ – нужно обратиться к специалисту и пройти полное обследование с учетом особенностей своего организма и семейного анамнеза. Что оно в себя включает, подскажет лечащий врач.